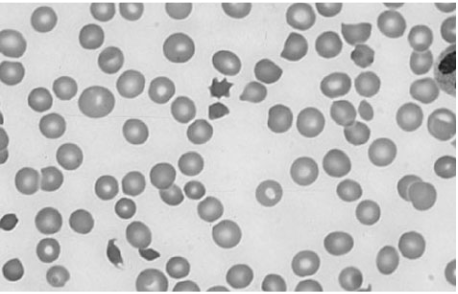

1.
A 66-year-old retired carpenter presents with
chronic shortness of breath upon exertion. He
has smoked one pack of cigarettes per day for
the past 5 years and drinks alcohol regularly.
Physical examination reveals a displaced point
of maximal impulse and hepatosplenomegaly.
His medications include pantoprazole for gas-
troesophageal refl ux and sertraline for depres-
sion. Echocardiogram reveals an ejection frac-
tion of 30% and dilated left and right ventricles.
Laboratory tests show:
Na+: 129 mEq/L
K+: 5.2 mEq/L
Cl−: 101 mEq/L
Blood urea nitrogen: 45 mg/dL
Creatinine: 1.3 mg/dL
Glucose: 134 mg/dL
Aspartate aminotransferase: 220 U/L
Alanine aminotransferase: 140 U/L
Alkaline phosphatase: 280 U/L
Which of the following is the most likely cause
of his cardiac findings?
(A)Borrelia burgdorferi
(B) Cigarette smoking
(C) Coxsackie B virus
(D) Ethanol
(E) Pantoprazole toxicity
(F)Trypanosoma cruzi
- The correct answer is D.
Dilated cardiomy-
opathy (DCM) is a common cause of conges-
tive heart failure (CHF). It is usually due to
causes such as ische mic heart disease or hyper-
tension, but in this case, it is likely due to the
toxic effects of chronic alcohol consumption.
The liver function tests and physical examina-
tion results are consistent with chronic alcohol-
ism and alcoholic cirrhosis.
2.
A 52-year-old man presents to his primary care
physician’s offi ce for routine care. He has hy-
pertension, hypercholesterolemia, and type 2
diabetes mellitus, and has smoked one pack of
cigarettes per day for the past 30 years. Medica-
tions include hydrochlorothiazide, atorvastatin,
and glipizide. There is a family history of myo-
cardial infarction in the maternal grandfather
at age 60. The patient has undergone screen-
ing for colon and prostate cancer. Physical ex-
amination reveals a pleasant, obese man who is
175 cm (5′9′′) tall and weighs 108 kg (238 lb).
His blood pressure is 155/81 mm Hg, heart rate
is 78/min, respiratory rate is 14/min, and tem-
perature is 36.8°C (98.3°F). What one action
would most reduce the patient’s stroke risk?
(A) Blood glucose reduction
(B) Blood pressure reduction
(C) Serum cholesterol reduction
(D) Smoking cessation
(E) Weight loss
- The correct answer is B.
Hypertension is the
most important controllable risk factor for
stroke, and the stroke risk attributable to this
patient’s high blood pressure is larger than any
other factor. The other answers, although im-
portant for improving the patient’s health and
longevity, are less tightly correlated to reducing
stroke risk.
3.
A 36-year-old man presents to the clinic with
complaints of a genital sore. The patient is a
sexually active heterosexual involved with
three partners and practices unprotected inter-
course. Fours days ago he noted a painless sore
on his penis. He is afebrile, with a heart rate of
80/min and blood pressure of 120/77 mm Hg.
Physical examination reveals a solitary ulcer-
ated lesion located on the lateral aspect of his
penis. The lesion is nontender and associated
with bilateral inguinal lymphadenopathy. Phys-
ical examination is otherwise normal. If left
untreated, this man is at increased risk for
which of the following?
(A) Ascending aortic aneurysm
(B) Coronary artery aneurysm
(C) Endocarditis
(D) Mitral valve stenosis
(E) Rupture of ventricular free wall
- The correct answer is A.
The patient presents
with primary syphilis. The lesion is typically a
single painless papule that rapidly becomes
eroded and indurated. Chancres are usually lo-
cated on the penis in heterosexual males but in
homosexual males may be found in the anal
canal, mouth, or external genitalia. In females
they may be seen on the cervix or labia. Serol-
ogy or dark fi eld microscopy can be used to
confi
rm the diagnosis. If left untreated, the pa-
tient may progress to secondary and tertiary
syphilis. Tertiary syphilis causes disruption of
the vasa vasorum or the aorta and consequent
dilation of the aorta, often involving the aortic
root or ascending aorta. This can result in an-
eurysm of the ascending aorta and aortic valve
incompetence.
4.
An 81-year-old man is hospitalized for acute
onset of shortness of breath and lower extrem-
ity edema. Although he lives by himself, it is
very difficult for him to move around his apart-
ment without experiencing fatigue. He has not
seen his physician in years but was told in the
past that he had high blood pressure. On physi-
cal examination his jugular venous pulse is pal-
pated 9 cm above his sternal notch, inspiratory
crackles are heard at his lung bases, and there
is 3+ lower extremity edema. Which of the fol-
lowing will confirm the most likely diagnosis?
(A) Cardiac angiography
(B) Echocardiography
(C) Electrocardiogram
(D) Endomyocardial biopsy
(E) Pulmonary function tests
(F) X-ray of the chest
- The correct answer is B.
The patient most
likely has an acute CHF exacerbation with the
underlying etiology being hypertension.
Echocardiography is an essential test in all pa-
tients with newly diagnosed heart failure and is
an excellent, noninvasive method of assessing
chamber size, function, and ejection fraction.
5.
A 42-year-old man presents to the clinic for routine evaluation. His medical history is significant for gallstones. The patient denies smoking and drinks alcohol occasionally. His mother had a heart attack at the age of 63 years. His blood pressure is 134/77 mm Hg. The patient is overweight with well-healed laparoscopic cholecystectomy scars. Fasting laboratory tests show:
Aspartate aminotransferase: 37 U/L
Alanine aminotransferase: 28 U/L
Alkaline phosphatase: 88 U/L
Total cholesterol: 268 mg/dL
LDL cholesterol: 183 mg/dL
HDL cholesterol: 46 mg/dL
Triglycerides: 166 mg/dL
What is the most appropriate next step in management?
(A) A trial of lifestyle modification alone (diet,
exercise, and weight loss)
(B) A trial of lifestyle modification combined with statin and niacin therapy
(C) A trial of lifestyle modification combined with statin therapy
(D) Niacin therapy
(E) Statin therapy
- The correct answer is A.
You should be famil-
iar with the goals of cholesterol-adjusting ther-
apies. This patient has only one risk factor
(family history) and his goal of LDL choles-
terol is 160 mg/dL or less. Therapeutic lifestyle
changes in the form of a 12-week trial of diet,
exercise, and weight loss should be attempted
given his current LDL cholesterol level.
6.
Two and a half weeks after coronary artery by-
pass grafting, a 63-year-old man returns to the
emergency department acutely short of breath.
The patient states that he began having chest
pain and shortness of breath approximately 1
hour earlier. He has a history of hypertension,
diabetes, and two myocardial infarctions. On
examination he is hypoxic with an oxygen satu-
ration of 86% on room air. Other vital signs
and results of a physical examination are nor-
mal. ECG shows no interval change from his
most recent ECG. CT of the chest is shown in
the image. What is the most likely etiology of
this patient’s shortness of breath?
A) Aortic dissection
(B) Exacerbation of chronic obstructive pulmonary disease
(C) Myocardial infarction
(D) Pleural effusion
(E) Pulmonary embolus

- The correct answer is E.
Recent surgery and
likely limited mobility in the postoperative pe-
riod are two risk factors for pulmonary em-
bolus. The enhanced CT scan of the chest
shows a fi lling defect within the right pulmo-
nary artery consistent with pulmonary em-
bolus. The patient should be treated with anti-
coagulation. Other common risk factors for
deep venous thrombosis and pulmonary em-
bolus include malignancy, pregnancy, and hy-
percoagulable states.
7.
A 72-year-old man with coronary artery disease
and hypertension is hospitalized after suffering
a myocardial infarction 5 days ago. He sud-
denly complains of severe chest pain. His
blood pressure is 90/60 mm Hg and heart rate
is 65/min. Auscultation reveals no murmurs or
rubs. An ECG reveals sinus rhythm with an
acute ST-segment elevation in the anteroseptal
area. Urgent bedside echocardiography showed
anteroseptal, lateral, and apical akinesis, mild
left ventricular systolic dysfunction, and severe
pericardial effusion. Within 20 minutes he is
unconscious with undetectable pulses and
blood pressure. What is the most likely cause
of the patient’s sudden decompensation?
(A) Free wall rupture
(B) Left ventricular thrombus
(C) Mitral regurgitation
(D) Pericarditis
(E) Ventricular septal rupture
- The correct answer is A.
Myocardial rupture is
a sudden postinfarction complication that typi-
cally occurs 5–10 days after an MI (peak at 7
days). During this time the integrity of the car-
diac wall is compromised by macrophage and
mononuclear infiltration, fi brovascular re-
sponse, and other infl ammatory mediators, as
they replace necrotic tissue with scar tissue.
Old age, fi rst MI, and a history of hypertension
are risk factors. The clinical manifestations, as
seen here, are a sudden loss of heart rate, blood
pressure, and consciousness, while the ECG
continues to show a sinus rhythm. Measures to
prevent cardiac rupture include the administration of
β-blockers, angiotensin-converting en-
zyme (ACE) inhibitors, and the avoidance of
steroidal and nonsteroidal anti-inflammatory
agents such as ibuprofen and indomethacin.
8.
A 56-year-old woman was recently started on
medication for high blood pressure. At her next
office visit her hypertension is under good control, but
she now complains of “feeling strange”
since she started the medication. On further
questioning, she reports feeling chest tightness
several times over the past 2 weeks, and has
also noticed pain in her elbows and knees. Her
blood pressure is 124/78 mm Hg (146/82 mm
Hg on last visit), heart rate is 102/min, and respiratory
rate is 14/min. Her examination is notable for
several erythematous plaques on the
malar distribution of the face, arms, and upper
torso. What medication was she most likely
started on during her last visit?
(A) Captopril
(B) Furosemide
(C) Hydralazine
(D) Metoprolol
(E) Verapamil
- The correct answer is C.
This patient displays
symptoms of angina, tachycardia, rash, and
joint pains. This lupus-like syndrome is a well-
described adverse effect of hydralazine therapy.
The vasodilatory action of hydralazine can re-
sult in refl ex tachycardia and decreased oxygen
delivery to the myocardium in patients with ex-
isting CAD. Other agents known to cause a sys-
temic lupus erythematosus-like syndrome in-
clude isoniazid, procainamide, and phenytoin.
9.
A 19-year-old woman was attacked while com-
ing home from a party and is brought to the
emergency department. She recalls being
punched in the side of the head and stabbed in
the left flank. Her speech is slow and she com-
plains of a bad headache. Her pulse is 110/
min, blood pressure is 90/50 mm Hg, and re-
spiratory rate is 25/min. On examination she
has a stab wound at the left costal margin in
the midaxillary line. Two large-bore intrave-
nous lines are inserted, and after infusion of
2 L of lactated Ringer’s solution her blood
pressure rises to 95/55 mm Hg. What is the
most appropriate next step in management?
(A) Abdominal ultrasound
(B) Diagnostic peritoneal lavage
(C) Exploratory laparotomy
(D) Noncontrast CT of the head
(E) Peritoneal laparoscopy
The correct answer is C.
A stab wound in a
patient who is hemodynamically unstable re-
quires immediate exploratory laparotomy. This
patient is in shock, and the source of bleeding
should be found.
10.
A 48-year-old man presents to the emergency
department complaining of crushing subster-
nal chest pain. He is diaphoretic, anxious, and
dyspneic. His pulse is 110/min, blood pressure
is 175/112 mm Hg, respiratory rate is 30/min,
and oxygen saturation is 94%. Aspirin, oxygen,
sublingual nitroglycerin, and morphine are
given, but they do not relieve his pain. ECG
shows ST-segment elevation in leads V2 to V4.
The duration of symptoms is now approxi-
mately 30 minutes. What is the most appropriate
treatment for this patient at this time?
(A) Calcium channel blocker
(B) Intravenous angiotensin-converting enzyme inhibitor
(C) Intravenousβ-blocker
(D) Magnesium sulfate
(E) Tissue plasminogen activator
- The correct answer is E.
This patient is pre-
senting with a classic acute MI, and he has ful-
fi lled all indications for fibrinolytic therapy:
acute chest pain suggesting MI, time to ther-
apy <12 hours, and ST-segment elevation >2–3
mm in the chest leads and 1 mm in the limb
leads. Contraindications to fibrinolytic therapy,
however, must still be ruled out; these include
a history of intracranial hemorrhage, acute
ischemic stroke within the past 3 months, cere-
brovascular malformation or brain metastasis,
suspicious aortic dissection, active internal
bleeding or bleeding diathesis, and significant
head trauma within the past 3 months.
11.
A 70-year-old woman presents to the emer-
gency department complaining of dizziness.
She is disoriented to the date and her location
and it is difficult to gather an accurate history.
Her pulse is 48/min, blood pressure is 84/60
mm Hg, and respiratory rate is 12/min. On
examination her extremities are cool and
clammy. Her capillary refi ll time is 5 seconds.
What is the most appropriate therapy?
(A) Adenosine
(B) Amiodarone
(C) Atropine
(D) Isoproterenol
(E) Metoprolol
- The correct answer is C.
This patient has symp-
tomatic bradycardia as evidenced by her altered
mental status and hypoperfusion. In an elderly
patient, it is most likely caused by an inferior
wall MI or sick sinus syndrome, but certain
medications like nitroglycerin,
β-blockers, ACE
inhibitors or barbiturates can mimic a shock-like
state. Atropine is the drug of choice for symp-
tomatic bradycardia.
12.
A 77-year-old man, complaining of abdominal
pain, anorexia, and nausea and vomiting over
the past 24 hours, presents to the clinic with
his son. The son reveals that his father has also
complained of blurred vision. The patient’s vi-
tal signs are stable and his abdomen is soft, but
he appears to be somewhat confused. He is
currently taking metoprolol, digoxin, and hy-
drochlorothiazide for ischemic congestive
heart failure. His son says that sometimes his
father confuses his medications. The patient
also has renal insuffi ciency with a baseline se-
rum creatinine of 2.6 mg/dL. The ECG reveals
a widened QRS complex and a new first-degree heart
block. Which of the following is the most
likely cause of this patient’s symptoms?
(A) Digoxin toxicity
(B) Gastroenteritis
(C) Hypocalcemia
(D) Hypovolemia secondary to thiazide diuretic overuse
(E) Myocardial infarction
- The correct answer is A.
Digoxin toxicity often
presents with vague abdominal complaints, ac-
companied by neurologic (headache, delir-
ium) complaints; visual (altered color percep-
tion, scotomata) complaints; and, most notably,
cardiac arrhythmias. This patient may have
taken too many digoxin pills. Measurement of
the plasma digoxin level will help confirm the
diagnosis (therapeutic range is 0.5–2 ng/mL).
However, toxicity can also exist at normal lev-
els, particularly in persons who are elderly. Be-
cause digoxin is renally excreted, the patient
may have acute renal failure precipitating his
toxicity; this must be investigated. Note that
digoxin levels taken within 6–8 hours of inges-
tion do not refl ect the steady state and are not
reliable predictors of prognosis. Antidigoxi-
genin antibody Fab fragments are first-line
therapy in the setting of life-threatening arrhythmia.
13.
A 35-year-old woman presents to the clinic be-
cause of visual problems. She states that she
has always had diffi culty looking up, and over
the past few years her overall vision has be-
come blurry. Review of symptoms is notable
for several recent episodes of “near fainting.”
She takes no medication and has no other
medical history, and has not seen a physician
for 7 years. Because she was adopted as a child,
she does not know her family history, but her
son has required special tutoring at school. The
patient also remarks that her son seems to have
been dropping objects lately. Physical exami-
nation reveals bilateral ptosis. Her extraocular
movements are intact and the pupils are equal,
round, and reactive. Her corrected visual acu-
ity is 20/100 in the right eye and 20/120 in the
left eye. The view of the fundus is obscured.
On ambulation she raises her knees and makes
a slapping sound on the fl oor as she walks.
ECG indicates heart block. What is the patho-
genesis of this patient’s disorder?
(A)
Borrelia burgdorferi
infection
(B) Deletion mutation in dystrophin
(C) Frameshift mutation in dystrophin
(D) Trinucleotide repeat expansion
(E) X-linked emerin defi
ciency
- The correct answer is D.
This patient is suffer-
ing from myotonic dystrophy, a muscular dys-
trophy caused by multiple CTG nucleotide re-
peats within the myotonin protein kinase gene.
With successive generations, the number of
CTG sequences increases parallel with earlier
onset of symptoms and more severe disease (ge-
netic anticipation). This accounts for the likely
onset of weakness already in the patient’s son.
Patients often present with ptosis and weakness
of the facial muscles, giving a characteristic
“hatchet face” appearance. Another common
presentation is weakness and atrophy of the in-
trinsic hand muscles and forearm extensors.
Cardiac abnormalities, particularly disease of
the conduction system, can lead to syncopal epi-
sodes or even sudden death. Heart block can be
progressive, sometimes necessitating placement
of a pacemaker. The hallmark of disease is myo-
tonia, which is tonic spasm of affected muscles.
Pharmacologic therapy for myotonia includes
phenytoin, procainamide, or quinine sulfate,
but this does not improve the weakness, cardiac
abnormalities, or overall course of the disease.
14.
A college sophomore is found by his roommate
to be poorly responsive and brought to the
emergency department. After resuscitation, the
man complains of a severe headache and pho-
tophobia that is accompanied by dizziness,
nausea, vomiting, and neck pain. Physical ex-
amination is noteworthy for positive Kernig’s
and Brudzinski’s signs as well as petechiae on
the trunk and mucocutaneous bleeding. Labo-
ratory studies show:
WBC count: 17,000/mm³
Hemoglobin: 11 g/dL
Platelet count: 70,000/mm³
Bleeding time: 10 min
Prothrombin time: 17 sec
Activated partial thromboplastin time: 47 sec
Thrombin time: 18 sec
A peripheral blood smear is shown in the im-
age. Which of the following is the most likely
diagnosis?
(A) Disseminated intravascular coagulation
(B) Factor V Leiden
(C) Immune thrombocytopenic purpura
(D) Protein C deficiency
(E) Thrombotic thrombocytopenic purpura
- The correct answer is A.
Disseminated intra-
vascular coagulation (DIC) is a consumptive
coagulopathy that has been associated with a
number of clinical conditions, including bacte-
rial infections such as meningococcemia. DIC
involves activation of the coagulation pathways,
excessive fi brin formation, and platelet activa-
tion. Subsequent bleeding results because of
the depletion of coagulation factors and plate-
lets in the circulation. Because of the con-
sumption of coagulation factors and activation
of platelets, patients present with prolonged
bleeding time, prothrombin time, activated
partial thromboplastic time, and thrombin
time; thrombocytopenia; and schistocytes on
peripheral blood smear. Although not specific,
the presence of D-dimer and fibrinogen degra-
dation products supports a diagnosis of DIC.
15.
A 60-year-old man with coronary artery disease,
peptic ulcer disease, and gout presents to the
emergency department with a 24-hour history
of abdominal pain. The pain, which is most in-
tense in the upper abdomen, was sudden in
onset and has become progressively more se-
vere. Free air in the abdomen is detected on
x-ray fi lms. The patient is in an agitated state.
His extremities are cool and capillary refi
ll
time is 3 seconds. His blood pressure is 80/40
mm Hg and heart rate is 130/min. The neck
veins are fl at and the lungs are clear to auscul-
tation. His hemoglobin is 13.8 g/dL. A urinary
catheter is inserted and 10 mL of urine is
drained. What is the most appropriate treat-
ment for this patient at this time?
(A) Broad-spectrum antibiotics for presumed
sepsis
(B) Infusion of isotonic fl
uid
(C) Infusion of norepinephrine
(D) Inotropic support with dopamine, vaso-
pressin, or dobutamine
(E) Transfuse with 1 unit packed RBCs
- The correct answer is B.
This patient is most
likely suffering from hypovolemic shock sec-
ondary to perforation of a peptic ulcer, which
is confi rmed by the fi nding of free air in the
abdomen. Initial resuscitation requires rapid
reexpansion of the effective blood volume
along with interventions to control ongoing
losses. This is best accomplished with a rapid
infusion of isotonic saline or lactated Ringer’s
solution through two large-bore intravenous
lines.
16.
A 29-year-old woman presents to the emer-
gency department with a 3-week history of be-
ing awakened by a dull, prolonged chest pain
that occurs 3–4 times a week. She is a smoker
but has never suffered a myocardial infarction
(MI) or had chest pain before and has no fam-
ily history of early MI. Results of a 12-lead
ECG are normal. Her fi rst set of cardiac en-
zyme measurements (creatine kinase, creatine
kinase-MB fraction, troponin I) are negative. If
coronary angiography were taken at the time of
her chest pain, which of the following fi
ndings
is most like?
(A) Coronary artery spasm
(B) Greater than 80% stenosis in at least two
coronary arteries
(C) No abnormal fi
ndings
(D) Plaque rupture and thrombosis
- The correct answer is A.
This patient most
likely suffers from Prinzmetal’s angina, which
is caused by coronary artery spasm. This type
of angina usually occurs in smokers younger
than those with unstable angina (UA) due to
atherosclerotic disease. The pain is intermit-
tent and can wake them up in the morning.
During chest pain, an ECG will show multi-
lead ST-segment elevations that can resolve
with the administration of nitroglycerin.
17.
A 42-year-old man presents to the emergency
department with a complaint of increasing
shortness of breath when walking to get his
newspaper, diffi culty breathing while lying fl
at,
and a 4.5-kg (10-lb) weight gain over the past
month. He is afebrile, his pulse is 75/min, and
his blood pressure is 98/50 mm Hg. On exami-
nation he smells of alcohol and has 2+ pitting
edema in the lower extremities and a third
heart sound. X-ray of the chest reveals cardio-
megaly. What additional fi ndings must be pres-
ent to confi rm this man’s underlying diagnosis?
(A) Hepatojugular refl
ux and pulmonary con-
gestion
(B) Left ventricular dilation and aortic insuffi
-
ciency
(C) Left ventricular dilation and systolic dys-
function
(D) Myocardial thickening and diastolic dys-
function
(E) Pulmonary congestion and diastolic dys-
function
- The correct answer is C.
The patient has
DCM, a diagnosis that requires evidence of LV
dilation and systolic dysfunction with LV ejec-
tion fraction (LVEF) <40% on echocardiogra-
phy. Dilation of the LV results in decreased
ability to contract and eject blood from the
chamber, resulting in a decreased LVEF. Pa-
tients usually present with symptoms of heart
failure, arrhythmias, or even sudden death.
Fifty percent of cases are of idiopathic etiology
but the most common known causes are isch-
emic cardiomyopathy due to CAD, myocardi-
tis, and infi ltrative disease. Alcohol is a poorly
understood but signifi cant risk factor for DCM,
and abstinence can result in remarkable recov-
ery of cardiac function.
18.
A 69-year-old man with rheumatic heart dis-
ease presents to the emergency department
complaining of a fever and weakness on his left
side. On physical examination the patient is
weak in his left upper extremity and he draws
only the right half of a clock. Shortly after his
presentation, the patient dies, and an autopsy
is performed. A gross view of the patient’s heart
is shown in the image. Which of the following
is a risk factor for the type of lesion pictured?
(A) Coronary artery disease
(B) Hypertension
(C) Mitral valve prolapse
(D) Prolonged bedrest
(E) Prosthetic valve replacement

- The correct answer is C.
The photograph de-
picts a vegetative growth on a native mitral
valve. Mitral valve prolapse (MVP), particu-
larly as a complication of rheumatic heart dis-
ease, is a risk factor for native valve infective
endocarditis. This is because altered blood flow
around a damaged valve provides the opportu-
nity for a clot to develop and harbor bacteria,
which gain access to the blood through a
wound, dental work, surgery, or intravenous
drug use. It can be prevented by replacing the
valve with a prosthetic valve.
19.
A 28-year-old man with a history of intravenous
drug abuse presents to the emergency depart-
ment with a 2-day history of fever, chills, and
shortness of breath. On physical examination
the patient has a new heart murmur, small reti-
nal hemorrhages, and subungual petechiae.
Which of the following is the most likely caus-
ative organism?
(A) Group A Streptococcus
(B) Mycobacterium tuberculosis
(C) Staphylococcus aureus
(D) Staphylococcus epidermidis
(E) Streptococcus viridans
- The correct answer is C.
In patients with in-
fective endocarditis and a history of intravenous drug
abuse, Staphylococcus aureus is the
causative agent in the vast majority of cases
and is more likely to cause acute rather than
subacute endocarditis. If the patient has a pros-
thetic valve, then coagulase-negative staphylo-
coccus is the predominant organism. Bacterial
endocarditis is an infectious process of the en-
dothelial surface of the heart. Symptoms in-
clude fever, fatigue, malaise, vascular phenom-
ena such as Janeway lesions, and immunologic
phenomena such as Osler nodes. Diagnosis is
usually based on the Duke criteria, and labora-
tory studies include blood culture and echocar-
diography. Treatment is through intravenous
antibiotics and surgery for valve repair or re-
placement, if necessary.
20.
A boy is delivered at 37 weeks’ gestation via
spontaneous vaginal delivery. He is the prod-
uct of a normal pregnancy and was delivered
without complications. Prenatally the mother
was blood type B and was rubella immune and
negative for Rh antibody, group B streptococci,
rapid plasma reagin, hepatitis B surface anti-
gen, gonorrhea, and chlamydia. The patient
appears cyanotic. He is breathing at a rate of
60/min and his heart rate is 130/min. He has a
normal S1 and S2. There is a harsh holosys-
tolic murmur that is loudest at the left lower
sternal border. His examination reveals palpa-
ble nonbounding peripheral pulses bilaterally.
Which of the following is the most likely diag-
nosis?
(A) Coarctation of the aorta
(B) Dextraposed transposition of the great ar-
teries
(C) Patent ductus arteriosus
(D) Tetralogy of Fallot
(E) Truncus arteriosus
- The correct answer is B.
Dextraposed transpo-
sition of the great arteries (D-TGA) is the most
common cause of cyanotic heart disease in neonates.
It accounts for 5% of congenital heart
defects. With this defect, the aorta arises from
the right ventricle and the pulmonary artery
arises from the LV. This leads to pulmonary
and systemic circuits that are in parallel as op-
posed to in series. The deoxygenated blood is
therefore recirculated through the body in the
systemic circulation, while the oxygenated
blood only fl ows through the pulmonary circu-
lation. A lesion, such as an atrial septal defect
(ASD), ventricular septal defect (VSD), or pa-
tent ductus arteriosus (PDA), is therefore re-
quired for mixing of the systemic and pulmo-
nary circulations for survival. D-TGA usually
presents at birth with cyanosis and tachypnea.
Plain fi lm radiographs demonstrate an egg-
shaped silhouette due to the absent main pul-
monary artery stem and small heart base. Pros-
taglandin E1 is used to keep the PDA open and
increase mixing of deoxygenated and oxygen-
ated blood. Balloon atrial septostomy can also
be used if necessary. An arterial switch surgical
procedure is used to repair the defect.
21.
A 32-year-old man is stabbed in the left chest
and presents to the emergency department in
distress. His pulse is 130/min, blood pressure is
70/50 mm Hg, and respiratory rate is 39/min.
The stab wound is in the left fifth intercostal
space in the midaxillary line. On examination
his trachea is deviated to the right, jugular
veins are distended bilaterally, and he has ab-
sent breath sounds and hyperresonance to per-
cussion on the left side. Subcutaneous emphy-
sema is palpated on the left thoracic wall.
What is the best next step in management?
(A) Chest tube thoracotomy
(B) Diagnostic peritoneal lavage
(C) Needle thoracostomy
(D) Pericardiocentesis
(E) Surgical exploration
- The correct answer is C.
This patient pre-
sented with a tension pneumothorax, which re-
sults from a parenchymal wound that acts as a
one-way valve that allows free air into the pleu-
ral space but prevents its escape, causing col-
lapse of the lung on the affected side. It is a
medical emergency, as the building pressure in
the pleural space causes shifting or displace-
ment of the mediastinum to the contralateral
side and subsequently compromises cardiopul-
monary function. Compression of the opposite
lung impairs proper gas exchange while im-
pingement on the heart impairs proper cardiac
function. The most common mechanisms of
this type of injury are blunt or penetrating in-
juries, or secondary to medical procedures. A
large-bore needle should be inserted in the sec-
ond intercostal space in the midclavicular line
to facilitate decompression and reestablish car-
diopulmonary function. The needle is left in
place until a thoracostomy tube can be inserted.
22.
A 75-year-old man comes into the emergency
department with a 10-minute history of crush-
ing substernal chest pain radiating to his left
arm. This man is well known to the staff due to
his long history of chest pain. His creatine
phosphokinase level is elevated and his tro-
ponin T level is 0.4 ng/mL. Which of the fol-
lowing is the most likely diagnosis?
(A) Acute myocardial infarction
(B) Hypochondriasis
(C) Prinzmetal’s angina
(D) Stable angina
(E) Unstable angina
- The correct answer is A.
This man has a car-
diac enzyme leak of specifi c myocardial mark-
ers that suggests acute MI. UA is defi ned as ei-
ther rest angina >20 minutes in duration,
new-onset angina, or increasing angina that is
more frequent, longer in duration, or occurs
with less exertion than previous angina. UA
and non-ST-segment elevation MI (NSTEMI)
are part of the continuum of acute coronary
syndromes, in which plaque rupture and coro-
nary thrombosis compromise blood fl ow to a
region of viable myocardium. In UA and
NSTEMI, ST-segment elevation and patho-
logic Q waves are absent. They are treated with
medical management (antiplatelet therapy, ni-
troglycerin, β-blockade, and morphine), and
considered for revascularization.
23.
A 91-year-old woman presents to the emer-
gency department with a chief complaint of
shortness of breath over the past 2 days. She
has a history of hypertension and coronary ar-
tery bypass surgery 25 years earlier. Her blood
pressure is 178/92 mm Hg and she has jugular
venous distension, hepatomegaly, and 3+ lower
extremity edema. ECG is remarkable for left
ventricular hypertrophy, no ST-segment eleva-
tions or depressions, no Q waves, and no T-
wave abnormalities. Echocardiogram reveals
an ejection fraction of 60% and left atrial dila-
tation. There is universal left ventricular thick-
ening. No valvular regurgitation or stenosis was
noted. Which of the following underlying con-
ditions is the most likely cause of this patient’s
symptoms?
(A) Hypertensive heart disease
(B) Hypertrophic obstructive cardiomyopathy
(C) Ischemic heart disease
(D) Mitral valve prolapse
(E) Myocarditis
- The correct answer is A.
You should be able to
recognize diastolic dysfunction as a cause of
heart failure. In diastolic heart failure, LVEF is
normal (>50%). Heart failure results from an
inability of the LV to fi ll during diastole rather
than an inability of the LV to eject blood into
systemic fl ow. Hypertensive heart disease is one
of the most common causes of diastolic heart
failure. This patient’s medical history of hyper-
tension, in-offi ce measurement indicating high
blood pressure, and the ECG showing LVH is
consistent with this diagnosis.
24.
A 39-year-old white man with essential hyper-
tension presents for a routine health mainte-
nance visit. He has no complaints and reports
compliance with his hydrochlorothiazide. His
pulse is 70/min, blood pressure is 145/92 mm
Hg, and respiratory rate is 16/min. His body
mass index is 24 kg/m². His physical examina-
tion is within normal limits. For which condi-
tion is the patient at increased risk?
(A) End-stage renal disease
(B) Hypercholesterolemia
(C) Hypertrophic cardiomyopathy
(D) Second-degree Mobitz I atrioventricular
block
(E) Type 2 diabetes mellitus
- The correct answer is A.
Hypertension is a risk
factor for both chronic renal insufficiency and
end-stage renal disease. Hypertension can di-
rectly cause renal disease and accelerate the
progression of underlying renal pathology. In
addition, hypertension increases a patient’s risk
of premature cardiovascular disease, heart fail-
ure, stroke, and intracerebral hemorrhage.





